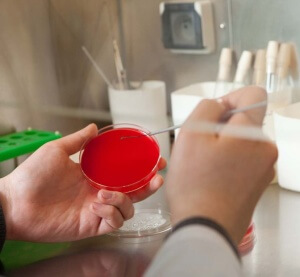

Стафилококк – это условно-патогенная бактерия. На самом деле пребывает на человеческом теле практически постоянно. При неблагоприятных обстоятельствах их число может резко возрасти. Часто это влечет за собой различные заболевания как с легкими, так и с довольно тяжелыми последствиями. Как проявляет себя стафилококк на разных участках организма и как с ним справиться?
Причины и пути заражения
Стафилококковая инфекция, присутствуя в организме, может вызывать тяжелые для здоровья последствия. Во многом это обусловлено состоянием иммунной системы. Так, как бактерия может стать источником серьезных заболеваний, нужно не медлить с визитом ко врачу и лечением. Не нужно забывать о профилактических мерах и укреплении иммунитета.
Для того, чтобы развилось заболевание, бактерии должны как-то попасть в организм. Обычно это происходит через поврежденные уязвимые участки слизистых оболочек и кожи. Так же человек может быть постоянным носителем бактерии и даже не догадываться об этом.
Золотистый стафилококк отличается устойчивость к внешним факторам и легко передается от человека к человеку. Эта бактерия способна жить на протяжении 12 часов под ярким солнцем, выдержать около 10 минут при температуре 150°С. Кроме того, микроб не боится перекиси водорода, раствора соли и этилового спирта.
Существуют следующие пути передачи инфекции:
- Воздушно-капельный путь. Микробы легко передаются от зараженного человека через кашель, чихание и даже просто дыхание.
- Бытовой путь. Стафилококк может проникнуть в организм через предметы быта, прямой кожный контакт. Чужое постельное белье и полотенца могут быть его источником.
- Недостаточная гигиена. Заразиться инфекцией через грязные руки несложно. На тех или иных предметах могут быть отходы жизнедеятельности больного.
- Воздушно-пылевой путь. Микробы могут обитать даже в пыли, которую мы вдыхаем вместе с воздухом.
- Медицинские инструменты. Большую опасность несут некачественно очищенные медицинские инструменты. Такое может случаться в силу устойчивости стафилококка к некоторым методам обработки.
Даже если бактерии попали в организм, это еще не значит, что они обязательно вызовут болезнь.
Однако, такое может случится при стечении некоторых обстоятельств:
- Произошло снижение иммунитета. Сюда можно отнести постоянные стрессовые ситуации, неполноценный сон, сезонное ослабление. Организм также может быть ослаблен на фоне приема антибиотиков.
- Хронические заболевания. Такие патологии, как сахарный диабет и нарушение функции щитовидной железы ухудшают иммунную систему.
- Внешние факторы. Низкие температуры тормозят работу ресничек эпителия носовой полости, снижая защитные свойства.
- Вирусные инфекции. Часто бактериальные осложнения развиваются на фоне вспышки ОРВИ или гриппа. Если иммунитет слабый, патологическая активность стафилококка возрастает.
- Длительное применение сосудосуживающих средств. Долгое использование капель приводит к нарушению целостности слизистых, после чего бактериям легче попасть в организм.
Причины для развития заболеваний могут быть самыми разнообразными. Считается, что в группу риска входят дети дошкольного возраста и пожилые люди.
Для минимизации риска заражения нужно следить за личной гигиеной и употреблять чистую пищу из проверенных источников.
Как распознать болезнь на разных участках, признаки стафилокока у взрослых
Подтвердить наличие в организме золотистого стафилококка стало возможно благодаря лабораторным исследованиям. Для этого делают анализ, используя биоматериал. В зависимости от ситуации берут мазок из горла, носа, конъюнктивы, уха или раны. Так же проводят диагностику кала либо ректального соскоба.
Результат может быть не только просто положительным или отрицательным. Если число бактерий не превышает норму и не отмечен их рост, это может быть вариантом нормы либо потребует коррекции.
Существуют симптомы, характерные для стафилококковой инфекции. Проявления во многом зависит от того, какой участок тела поражен.
Инфекция в горле
Очень часто золотистый стафилококк атакует именно горло, вызывая тонзиллит, фарингит или ларингит, инфекционное заражение характеризуется следующими признаками:
- резко повышается температура
- головокружение
- миндалины припухлые и покрасневшие
- гнойный налет
- неприятные ощущения во время глотания
- потеря аппетита
К этому перечню может добавиться вздутость лимфатических узлов. Стафилококковая ангина не поддается лечению пенициллином, хотя выглядит также, как стрептококковая.
Инфекция в носу
В огромном количестве случаев стафилококк может обитать в слизистой, не давая о себе знать. Под негативным влиянием окружающей среды и снижении иммунных сил начинает развиваться болезнь.
- рост температуры
- интоксикация
- покраснение области носа
- гнойнички
Бактерии могут вызвать такие недуги как гайморит и фронтит. Тогда больной будет ощущать заложенность и боль в носу, отдающую в лоб, озноб, слабость.
Инфекция нередко приводит к риниту с хроническим течением. Проявляется в виде затрудненного дыхания, отечности, выделений из носа, которые могут приобретать гнойный характер.
Поражения кожи
На коже стафилококк вызывает гнойники и воспалительные процессы. Наиболее распространены случаи, когда стафилококк проявляется пиодермией. Эта патология характеризуется гнойными поражениями волосяных устьев и локализуется на шее, области ягодиц и бедер.
Если на коже появились большие пузыри с мутной серой жидкостью, это пузырчатка. Возникает из-за токсического действия бактерий.
Из-за внедрения стафилококковой инфекции могут возникать следующие поражения кожных покровов: дерматиты, фурункулы, фолликулиты, экзема, абсцессы.
Наибольшую опасность несут патологии кожи лица и шеи, так как есть вероятность попадания микробов глубже. Менингит, гнойный абсцесс – крайне опасные осложнения.
Кишечные заболевания
Заражение бактериями через пищу, грязные руки и воду может вызвать болезни ЖКТ, основные симптомы:
- частые приступы рвоты
- диарея
- тошнота
- боли в области живота
Эти признаки могут появиться уже через полчаса-час после употребления некачественных продуктов и свидетельствуют о небольшой концентрации микробов. Если к ним добавились примеси крови или гной в каловых массах, высыпания на коже, значит число бактерий значительное.
Как правило, симптомы патологической активности золотистого стафилококка выражены ярко. Общая картина зависит от места его локализации, состояния иммунной системы и других факторов.
В некоторых случаях инфицирование может привести к тяжелым заболеваниям – абсцессам, менингиту, пневмонии, перитониту. При обнаружении признаков инфекции нужно как можно скорее обратиться в медицинское учреждение.
Более подробно о признаках стафилококка у взрослых и детей, о лечении заболевания — смотрим на видео:
Способы лечения стафилококковой инфекции
Лечение стафилококка входит в компетенцию многих специалистов: хирургов, отоларингологов, терапевтов, инфекционистов и других. Целесообразна консультация не одного доктора, а нескольких. На сегодняшний день существуют следующие способы лечения.
Терапия антибиотиками
Так как стафилококк – это бактерия, то одним из самых эффективных средств против нее будут антибиотики. Однако, тут не все так однозначно. При легких локальных формах и небольшой концентрации микробов антибиотикотерапия может даже вызвать ухудшение состояния больного.
Это происходит из-за дисбаланса микрофлоры под воздействием медицинских препаратов.
Если проявилась болезнь с тяжелым течением или бактерии попали в кровь, показан антибиотик. Стоит учесть, что стафилококк обладает устойчивостью к некоторым видам противомикробных лекарств.
Для лечения используют:
- Цефтриаксон
- Амоксиклав
- Оксациллин
- Офлоксацин и другие
Чтобы справиться с инфекцией, к приему антибиотиков нужно подходить очень серьезно. Курс нужно пройти полностью в рекомендуемой в конкретном случае дозировке. Если закончить применение раньше времени, бактерия может погибнуть не полностью и выработать резистентность к этому антибиотику.
Альтернативный метод: бактериофаг
Бактериофаги еще называют уничтожителями золотистого стафилококка. Недостаток в том, что некоторые штаммы бактерий не поддаются такому лечению. Чтобы терапия была успешной нужно предварительно определить чувствительность к бактериофагу. Эти препараты применяют как для местного лечения, так и в виде инъекций.
Народные средства
Народные средства в основном направлены на укрепление иммунитета и помощь организму в борьбе с инфекцией. Некоторые растения имеют антимикробные свойства, устраняют болевые ощущения и выводят токсины из организма. Нельзя лечить стафилококк самостоятельно, используя только методы народной медицины.
Для сборов берут следующие травы: шалфей, череда, чабрец, корень солодки, листья подорожника и эвкалипта, анис. Помогут побороть воспалительный процесс в носу и горле помогут липа и черная бузина. Часто используют малину, шиповник, черную смородину, барбарис.
Чтобы облегчить течение болезни применяют жаропонижающие средства, препараты от обезвоживания, антигистаминные. Для лечения кожных высыпаний применяют обыкновенную зеленку, которая отлично борется с инфекцией.
Стафилококк и беременность
Сама по себе беременность выступает тем временем, когда иммунитет понижается естественным образом. А это открытые двери для вирусов и бактерий. Опасность активности стафилококка повышается.
Нежелательность такой ситуации еще и в том, что беременным женщинам противопоказано использование большого количества медицинских препаратов.
Чаще всего бактерии атакуют горло и нос, как самые доступные слизистые оболочки. Отрицательно влияет запущенный кариес. Поэтому всем тем, кто находится в ожидании малыша показаны визиты к стоматологу и ЛОРу.
Заражение стафилококком может нести большую угрозу для плода и матери. Инфекция может дать такие серьезные осложнения, как:
- пневмония
- менингит
- гнойные высыпания
- ячмень
- угри
- перитонит
Микробы могут попасть внутрь и вызвать инфицирование плода и его оболочек.
Для беременной женщины возможны такие виды лечения:
- антибиотики, к сожалению без них будет трудно обойтись при тяжелых степенях заболеваний
- местные противомикробные средства
- препараты для повышения иммунитета
- масляные и спиртовые раствора хлорофилипта
- кварц
Заболевание стафилококковой инфекцией лучше предотвратить, чем лечить. Беременным необходимо обращаться ко врачу при первых проявлениях боли в горле и насморка.
Примерно у 80% населения стафилококк живет на слизистых оболочках. Какое-то время условно-патогенные микробы не причиняют никакого вреда организму. Однако любое снижение иммунитета может дать толчок к интенсивному размножению бактерий, и вот тогда стафилококки становятся причиной множества опасных заболеваний. Золотистый стафилококк наиболее опасный из всей группы этих болезнетворных микроорганизмов. Он провоцирует большинство ЛОР-болезней, кишечных инфекций, кожных недугов. Избавиться от заболевания, спровоцированного стафилококком, бывает весьма непросто.
Причины заражения золотистым стафилококком
Золотистый стафилококк — очень живучая бактерия. Он устойчив к замораживанию и высушиванию, сложно поддается влиянию ультрафиолетовых лучей и химикатов. В пыли микроорганизм способен прожить около 100 дней, а в высушенном виде — больше полугода.
Золотистый стафилококк является достаточно устойчивой бактерией
Бактерии выживают и в соленой воде, им не страшна перекись водорода, а температурный режим в 70 градусов они выдерживают более часа. Убивает стафилококк кипячение и раствор фенола, и то после часового воздействия на него.
Если человек не является носителем инфекции, заразиться ею вполне реально в обычной больнице. Стафилококки первые в списке бактерии, по данным исследованиям ВОЗ, которыми чаще всего заражаются в медицинских учреждениях.
Микроорганизмы передаются контактным и воздушно-капельным путем.
Занести в организм инфекцию возможно через:
- рукопожатия, дверные ручки, предметы личной гигиены;
- незащищенный сексуальный контакт;
- употребление немытых или несвежих продуктов;
- кровь во время беременности от матери к малышу;
- открытые раны или ожоги;
- медицинские инструменты, перевязочный материал;
- трещины на сосках во время грудного вскармливания.
В группе риска находятся инъекционные наркоманы, лица, которые наносят татуировку или делают пирсинг в сомнительном заведении. Беременные, новорожденные, пожилые люди, больные с пониженным иммунитетом или иммунодефицитом более склонны к заражению, поскольку защитная функция их организма наиболее уязвима к инфекциям.
Стафилококк может легко проникнуть в организм человека, который перенес тяжелое респираторную инфекцию, грипп, дисбактериоз. Рискуют заболеть и пациенты после хирургического вмешательства или длительной терапии антибиотиками, люди с нарушенной деятельностью кишечника.
Главная причина инфицирования — сниженный иммунитет человека.
Как распознать клинические проявления болезни?
Признаки инфекции в горле
Определить симптомы золотистого стафилококка у взрослых не просто. Патогенная бактерия способствует развитию многих заболеваний в горле: ларингита, фарингита, тонзиллита.
Заболевание напоминает гнойную ангину
А чаще всего признаки инфекции схожи симптомами гнойной бактериальной ангины:
- увеличение миндалин
- утрата аппетита
- резкое повышение температуры тела до 39-40
- припухлость лимфатических узлов
- сильная боль при глотании слюны
- сонливость, общая мышечная слабость
- покраснение и отек горла
- образование гнойничков и налета на слизистой оболочке
- нестерпимая головная боль
Поскольку эти симптомы характерны и для других заболеваний горла, для точной диагностики необходимо провести бактериологический посев (мазок) ротовой полости. Неправильное лечение стафилококковой инфекции способствует перерождению болезни в хроническую форму, что может привести к пневмонии.
Люди, страдающие от частых ангин, обострения хронического тонзиллита, обязательно должны пройти проверку на наличие золотистого стафилококка в горле.
Инфекция способна проникать вглубь организма и может дать осложнение на сердце, почки, костную систему.
Без микробиологического исследования определить возбудителя инфекции судя только по внешним симптомам невозможно.
Симптомы стафилококка в носу
Полость носа — одно из любимых мест обитания золотистого стафилококка. Его появлению способствует не только снижение общего иммунитета, но и местного.
Стафилококк размножается при определенных условиях
В результате переохлаждения, чрезмерного использования антибактериальных капель в нос, сосудосуживающих средств или при наличии сопутствующего вируса стафилококк начинает активно размножаться.
Общие симптомы инфекции такие же, как и при заболеваниях носоглотки: общая слабость, признаки интоксикации, покраснение кожи носа и возникновение гнойных образований.
Патогенная бактерия способна вызвать гайморит, по мере распространения инфекции, у больного отекают веки, появляется заложенность носа, боль в лице, отдающая в верхнюю челюсть или лоб.
Часто из-за бурного роста количества стафилококка развивается фронтит. Он характерен болевым синдромом в области лба, особенно над бровями. Выделения из носа увеличиваются по утрам, возможно головокружение.
При хроническом рините стафилококкового происхождения слизь из носа приобретает неприятный запах и зеленоватый оттенок.
Одними из наиболее частых признаков стафилококка является насморк с густой и вязкой слизью, зуд в носу, появление небольших гнойных прыщей внутри носовых ходов или под носом.
Стафилококк и кожные болезни
Основной симптом кожного стафилококка — сыпь разного рода. Чаще всего инфекция проникает вглубь кожных покровов, образовывая гнойные прыщи. В большинстве случаев бактерии поражают волосяные луковицы, потовые и сальные железы.
Золотистый стафилококк вызывает заболевания кожи
Золотистый стафилококк часто становится причиной множества болезней кожи:
- пиодермия (фурункул, карбункул, фолликулит, сикоз, гидраденит, остиофолликулит)
- рожистое воспаление
- флегмона, импетиго
- панацирий (воспаление околоногтевого валика)
- множественные абсцессы у детей (синдром ошпаренных младенцев)
Кожа на месте распространения инфекции всегда красная, отечная, прикосновение приносит боль. При фурункулезе возникают крупные прыщи из которых сочиться гной, при рожистом воспалении сыпь незначительная, но температура тела может достигать 40, возможна тошнота или рвота.
Стафилококковая пиодермия характеризуется мелкими зудящими высыпаниями, которые после расчесывания распространяются на большие фрагменты кожи.
Размер высыпаний: от мелкой булавочной головки до небольшой детской ладошки (карбункул).
Помимо сыпи и повышенной температуры, иногда возникают признаки интоксикации в виде озноба и слабости тела, шелушение кожи, отслойка верхнего слоя кожи.
Кишечные заболевания
Поскольку стафилококк отлично адаптируется в окружающей среде, он зачастую размножается в продуктах питания с пройденным сроком годности. Любит бактерия селиться в жаркое время года в тортах, салатах с майонезом, пирожных с кремом. Очень часто золотистый стафилококк обнаруживают в рыбе, яйцах, молочных продуктах, мясе.
Первый симптом заражения инфекцией — ярко выраженные признаки кишечного отравления:
- тошнота и рвота
- диарея
- резкие режущие приступы боли в кишечнике, внизу живота
- спазмы, кишечные колики
Стул становится водянистый, постепенно вероятно появление в кале слизи или кровянистых примесей. Позывы в туалет могут достигать до 10 раз в сутки.
В результате временного обезвоживания у человека появляется слабость мышц, небольшой подъем температуры до субфебрильных показателей (37-37,5).
Если иммунитет больного очень слаб, то в таком случае существует риск развития инфекционно-токсического шока. Артериальное давление при этом падает значительно ниже нормы, человек может потерять сознание и впасть в кому.
Скрытый период отравления продуктами, зараженными золотистым стафилококком, длится недолго, симптомы проявляются уже в течение 2-4 часов после употребления их в пищу.
О симптомах золотистого стафилококка узнайте из предложенного видеоматериала.
Как лечить стафилококковую инфекцию?
Антибиотикотерапия
Избавиться от присутствия золотистого стафилококка в крови невозможно, а вот победить стафилококковую инфекцию вполне реально, хотя и сложно. Не все болезни, причиненные микроорганизмами, нуждаются в приеме антибиотиков.
К тому же, стафилококк устойчив к большинству известных антибиотиков, в том числе и к пенициллину. Зато бактерия крайне чувствительна к анилиновым красителям (обычной зеленке, которая есть в каждом доме).
Кишечная инфекция не всегда лечится антибиотиками
Кишечная инфекция, спровоцированная стафилококком, антибиотиками не лечится, отравление проходит самостоятельно. При заболеваниях носоглотки и кожи в большинстве случаев назначаются антибиотики:
- Цефуроксим, Цефалексин, Цефазолин
- Ванкомицин, Амоксиклав, Аугментин
- Флемоксин, Далацин, Тетрациклин
Кроме антибиотиков во время лечения стафилококковой инфекции пропить иммуностимулирующие препараты для восстановления защитной функции организма (Бронхомунал, Респиброн, Рибомунил), иммуноглобулины (Имудон).
Для местного применения используются:
- для носоглотки — обработка слизистых оболочек масляным или спиртовым раствором хлорофиллипта, ИРС-19;
- для кожи — мазь для наружного применения с мупироцином (Бактробан), Супироцин, Бондерм.
В арсенале врачей много вариантов для лечения стафилококковой инфекции, каждый случай должен рассматриваться индивидуально.
Народные методы
Снизить рост болезнетворных микроорганизмов ни одно народное средство не в силах, однако, некоторые рецепты помогают снять болезненные ощущения. Целители рекомендуют ввести в рацион абрикосовое пюре, его действие приравнивается к природному антибиотику. В день необходимо съедать не меньше 500 гр этого фрукта. Теми же свойствами обладает и черная смородина.
Для орошения носоглотки применяют народные средства
Для орошения носоглотки при стафилококке используются отвары лекарственных растений: ромашки, шалфея, корня лопуха, мать-и-мачехи, цветков календулы, подорожника.
Все травы обладают натуральным противовоспалительным и антисептическим свойством. Приготовить отвар просто: залить кипятком столовую ложку сухой травы, дать час настояться и промывать нос и горло не меньше 3-х раз в день.
Чтобы организм смог дать отпор болезни, народная медицина применяет настойки эхинацеи, женьшеня, отлично восстанавливает иммунитет отвар шиповника. Для горла рекомендуется сбор из душицы, барбариса, корня солодки и эвкалипта. Травы настаиваются полтора часа, для лучшего эффекта можно добавить немного меда.
Во избежание ожога слизистых оболочек кожи любой народный способ (дозировку трав, продолжительность приема) следует согласовать со специалистом.
Альтернативный способ: бактериофаги
Исходя из того, что золотистые стафилококк все больше адаптируется к современным антибиотикам, в последние годы популярность приобретают стафилококковые бактериофаги. Препарат действует на бактерию, проникая внутрь нее и разрушая изнутри. Бактериофаг убивает конкретный патогенный микроорганизм, в отличие от антибиотика широкого спектра, который разрушает и вредные и полезные бактерии.
Для назначения бактериофага нужно точная диагностика
Для того чтобы назначить такой препарат, врач должен точно диагностировать возбудителя болезни. Бактериофаги используются при лечении стафилококковой пневмонии, фурункулезе, остеомиелите, фарингите.
Курс лечения варьируется от 5 до 14 дней в зависимости от тяжести болезни. Производят медикамент в форме таблеток, свечей, аэрозолей и в жидкости для инъекций. Их применение оправдано для лечения беременных, кормящих мам, ведь бактериофаги не наносят вреда полезным микроорганизмам.
Побочные эффекты наблюдались редко, но пациенты все равно боятся его использовать. Бактериофаг относится к вирусам, его сложно отнести к какому-либо виду фармакологии. Однако этот препарат считается весьма эффективным в лечении золотистого стафилококка, и врачи часто применяют его на практике.
Обычно во время употребления бактериофагов не наблюдалось аллергической реакции, главное — соблюдать врачебные инструкции.
Как лечить инфекцию при беременности?
Беременные женщины находятся в группе риска
Беременные женщины первыми попадают в группу риска по инфицированию золотистым стафилококком. Их иммунитет существенно снижен и чувствителен к внешнему воздействию. Паниковать по поводу обнаружения бактерии в мазке не стоит. Если показатель стафилококка не превышает нормальные показатели, то никаких лекарств беременной принимать не нужно.
А вот стафилококковая инфекция чрезвычайно опасна и для мамы, и для ребенка. В результате заражения существует высокий риск пороков развития, а в тяжелых случаях самопроизвольный аборт.
Самолечение в данной ситуации запрещено. Гинеколог должен назначить женщине препараты, учитывая особенности ее беременности, наличие сопутствующих заболеваний. Острое течение болезни снимают антибиотиками щадящего действия, бактериофагами, иммуностимулирующими средствами.
Из местных средств применяют раствор Хлорофиллипта на масляной основе не меньше чем две недели. Во время лечения нельзя принимать ванну, греть зараженные участки тела. Под воздействием тепла бактерии размножаются еще быстрее и распространяются дальше по организму.
Для безопасности ребенка о существовании золотистого стафилококка в организме лучше узнать на этапе планирования беременности, предварительно сдав анализы.
С золотистым стафилококком люди с сильным иммунитетом живут годами, даже не догадываясь о его существовании. Поэтому так важно заботиться о своем самочувствии. Помимо стандартных правил здорового образа жизни, важно следить за гигиеной рук, тщательней выбирать продукты, проверять их срок годности. Необходимо мыть руки после посещения больницы, общественного транспорта, супермаркета. Большую часть бактерий, микробов и вирусов мы приносим домой на своих руках, на слизистых носа и горла. Все эти нехитрые правила помогут как можно реже болеть опасными заболеваниями, вызванными золотистым стафилококком.
Заметили ошибку? Выделите ее и нажмите Ctrl+Enter, чтобы сообщить нам.
Патогенные и полезные бактерии уживаются в человеческом организме, не доставляя проблем, только при условии соблюдения их пропорционального количественного соотношения. Нарушения баланса приводит к многочисленным заболеваниям. Стафилококк относится к условным патогенам, но в благоприятных условиях начинает активно размножаться. Превышение концентрации микроорганизма вызывает воспалительный процесс. Симптомы стафилококка у взрослых могут проявляться, практически, в любом органе. У детей бактерия, чаще, поражает пищеварительную систему, кожу и горло.
Краткое описание возбудителя
Стафилококк относится к бактериям Грамм+ (положительным). Имеет однослойную клеточную мембрану, плотные стенки и шарообразную форму.
Микроорганизм обладает двумя опасными свойствами:
- высокая вирулентность (способность заражать организм);
- устойчивость некоторых видов к антибиотикам.
На сегодняшний день медицине известно 34 вида (штамма) бактерий.
Проявление в человеческом организме характерно для трех из них:
- Эпидермальный. Локализуется на слизистых оболочках и эпидермисе (коже). Чаще всего, возникает на фоне сниженного иммунитета.
- Золотистый. Не имеет возрастных и гендерных критериев. Устойчив к солнечным лучам, высоким температурам, этанолу. Может поражать любые органы и системы человека. Обладает высокой токсичностью.
- Сапрофитный. Чаще развивается у женщин, вызывая болезни мочеполовой сферы. Хорошо поддается лечению.
Наиболее опасным является золотистый стафилококк, симптомы которого проявляются особенно активно, а лечение затруднительное. Болезни, вызванные этим штаммом, часто, сопровождаются осложнениями, поскольку бактерия обладает адаптивной способностью к ряду антибактериальных препаратов.
Причины развития стафилококка
На активность стафилококка в организме оказывают влияние экзогенные (внешние) и эндогенные (внутренние) факторы.
К первым относятся:
- пренебрежение правилами личной гигиены;
- контакт с больным человеком (воздушно-капельное инфицирование);
- употребление инфицированных продуктов питания;
- заражение стафилококком в медицинских учреждениях при несоблюдении персоналом стерильности.
Эндогенными факторами являются:
- ослабление защитных сил организма и сбои в работе иммунной системы;
- хронические эндокринные патологии;
- ВИЧ и СПИД;
- наличие открытых повреждений эпидермиса и слизистых.
Совокупность внешних и внутренних предпосылок способствует развитию инфекции в короткие сроки.
Симптоматика
Проявление стафилококка у взрослых обусловлено:
- местом дислокации инфекции (в какой системе или органе произошло заражение);
- активностью и концентрацией бактерий;
- способностью организма к сопротивлению (уровень иммунитета).
К общим признакам заболевания относятся:
- состояние интоксикации (тошнота, головокружение, вегетативные нарушения);
- гипертермия (повышение температуры тела);
- гнойные процессы в местах бактериальной инвазии (проникновения).
- нестабильное артериальное давление.
Чаще всего, инфекции подвержены:
- кожные покровы;
- желудочно-кишечный тракт;
- органы дыхания;
- слизистые оболочки.
Симптомы стафилококковой инфекции соответствуют болезням тех органов, где локализуются патогены, но проявляются более интенсивно, чем при неинфекционной этиологии (происхождении).
Эпидермис (кожный покров)
Кожные болезни могут развиваться в верхних слоях эпидермиса, а так же проникать глубоко внутрь, затрагивая не только ткани кожи, но и органов. В силу патогенной природы, стафилококк проявляется скоплением гноя в области заражения. Степень тяжести заболеваний зависит от масштаба и глубины инфекционно-воспалительного процесса.
Пиодермия
Это комплекс воспалительно-гнойных заболеваний, развивающихся вследствие нарушения защитного механизма кожи, и проникновения в нее патогенных микроорганизмов. Возникает, как воспаление корня волоса (фолликула) и смежных желез (сальной и потовой), с последующим нагноением. Распространенными участками локации являются шея, подмышечные и паховые складки, грудь.
Основные разновидности стафилококковой пиодермии:
- фолликулит, остиофолликулит (стафилококковое импетиго) – неглубокое поражение эпидермиса, небольшой гнойник;
- фурункулез (чирей) – инфекционное поражение волосяного фолликула, захватывающее близлежащие ткани, проникающее глубже, чем фолликулиты;
- карбункулез – глубокое поражение эпидермиса, подкожной клетчатки соседних фолликул, с острым гнойно-воспалительным течением;
- гидраденит – гнойное воспаление желез внешней секреции (потовых).
Экcфoлиaтивный дepмaтит (болезнь Риттера)
Характеризуется поражение всего кожного покрова, как при ожоге. Чаще всего, развивается у младенцев, вследствие заражения стафилококковой инфекцией в родильном доме. У взрослых легко переходит в эктиму – глубокую инфекционную язву.
Флегмона
Острое или хроническое нагноение подкожной клетчатки. Не имеет четких очертаний. Быстро прогрессирует, распространяясь в клеточных пространствах, и разрушая ткани. Может локализоваться вокруг определенного органа: парапроктит (прямая кишка), параметрит (матка), паранефрит (почки). Острая форма характеризуется тяжелым течением. При прорыве гноя внутрь организма вызывает поражение и разрушение тканей.
Слизистые оболочки
Возбудителем является золотистый стафилококк. Сосредоточение инфекции наблюдается в ротовой полости, слизистых носа и в горле у взрослых и детей, в области половых органов (влагалищный стафилококк) — у взрослых.
Горло
Основными заболеваниями являются стафилококковый тонзиллит и ларингит, реже фарингит. Симптоматика болезней чрезвычайно схожа. Дифференцировать их может только медицинский специалист.
Основные признаки стафилококковой инфекции горла:
- резкий скачок температуры (нередко до 40 градусов);
- отечность и гиперемия (переполнение кровью сосудов) слизистой оболочки и миндалин;
- гнойные скопления на эпителии (слизистой);
- головная боль;
- острые болезненные ощущения в горле, иррадиирующие (отдающие) в смежные органы (уши, шею);
- изменение голоса (осиплость, охриплость);
- отсутствие возможности глотать из-за боли;
- шейный лимфаденит (увеличение лимфоузлов).
При несвоевременном лечении инфекция поражает трахею, легкие и бронхи.
Поражение стафилококком носового эпителия может протекать бессимптомно. Проявление активности патогенов, как правило, спровоцировано простудными заболеваниями, обострением хронических отоларингологических болезней, снижением иммунитета.
Клиническими проявлениями являются:
- воспаление слизистой (ринит);
- выделения из носа с примесями гноя;
- заложенность носовых пазух;
- потеря обоняния;
- высокая температура.
Осложнениями могут быть гнойный гайморит или фронтит (воспаление придаточных или лобных пазух носа). Кроме того, гнойная инфекция быстро распространяется на органы дыхательной системы.
Ротовая полость
Инфекционное поражение полости рта может иметь экзогенный и эндогенный характер, а так же выступать в качестве осложнения стафилококка горла и носа.
Характеризуется:
- гипертермией;
- лимфаденитом;
- гнойным налетом;
- отечностью слизистой.
При наличии кариеса, пародонтоза, пульпита сопровождается зубной болью.
Половые органы
Проникновение инфекции во влагалище обусловлено:
- пренебрежением правилами интимной гигиены;
- незащищенным половым контактом;
- несоблюдением гинекологом стерильности во время осмотра.
На фоне низкого иммунитета, разбалансированной микрофлоры влагалища, наличия ранок, и хронических гинекологических болезней стафилококк отличается стремительным развитием, с проявлением следующих симптомов:
- обильные выделения с гнойными сгустками и резким запахом;
- болевой синдром внизу живота и в органах малого таза;
- ощущение зуда и жжения;
- пузырьки с гнойным содержимым на наружных половых органах;
- нарушение теплообмена.
При отсутствии надлежащей терапии развиваются инфекционные заболевания мочевого пузыря, уретры, протоков, внутренних половых органов.
Легкие
Острая инфекционно-гнойная патология, поражающая легочную серозную оболочку и ткани органа – стафилококковая пневмония, характеризуется тяжелым течением, и опасными осложнениями.
Основными признаками стафилококка легких у взрослых считаются:
- стабильно высокая температура тела;
- боли в области горла, спины (под лопаткой со стороны пораженного легкого);
- кашель с жидким отделимым (мокротой), с примесями кровяных и гнойных сгустков;
- тошнота, нередко рвота;
- затрудненное дыхание с характерным хрипящим звуком;
- расстройство стула;
- острый болевой синдром в груди и за грудиной при кашле и глубоком дыхании.
С течение времени может развиться сердечная декомпенсация.
Различают несколько разновидностей заболевания:
- буллезная — сама легкая форма с благоприятным прогнозом;
- абсцедирующая форма, опасна прорывом гноя во внутренние органы;
- метастатическая, чаще всего, имеет двустороннее расположение;
- легочно-плевральная имеет острое течение, при неблагополучном течение может спровоцировать развитие дыхательной недостаточности.
На рентгеновской диагностике определяются гнойные или полые (воздушные) кисты. Гнойный инфильтрат рассасывается очень медленно. В местах поражения легочная ткань замещается соединительной, возникает пневмосклероз.
Желудочно-кишечный тракт
При стабильной микрофлоре в кишечнике и нормальном уровне кислотности в желудке, стафилококк может не проявлять себя долгое время. Для его активизации необходим толчок в виде пищевого отравления или снижения функциональности иммунной системы.
Клинические проявления инфекции выглядят следующим образом:
- интенсивное опорожнение кишечника;
- жидкая консистенция экскрементов со слизью, нередко с кровяными сгустками;
- сильный болевой синдром в пупочной и эпигастральной (подложечной) области;
- рефлекторный выброс в начале содержимого желудка, потом желчи, через ротовую полость;
- кожный зуд, сыпь;
- субфебрильная (37,3 – 38°C) температура тела;
- дисфункции вегетативной системы (обмороки, головокружения);
- учащенный сердечный ритм (тахикардия).
Симптомы патогенной активности в кишечнике во многом схожи с проявлениями при интоксикации, чтобы не допустить осложнений, чрезвычайно важно во время распознать болезнь.
Распространенные осложнения
При заражении очень важно подобрать антибиотик, способный ликвидировать патогены, и начать лечение стафилококка. У взрослых велик риск осложнений на сердце, особенно при инфицировании горла и легких.
Неблагоприятными последствиями является проявление следующих заболеваний:
- Воспаление внутренней сердечной оболочки и сердечных сфинктеров (эндокардит). При переходе заболевания в хроническую стадию, возможен отрыв тромба и закупорка сосуда (тромбоэмболия), развитие сердечной недостаточности, частичный некроз тканей миокарда.
- Стафилококковый менингит. Гнойное воспаление мозговых оболочек и мозга. Характеризуется затяжным течением, возникновением психопатологий. Прогноз, в большинстве случаев, не благоприятный.
- СТШ или синдром токсического шока. Быстро прогрессирующая интоксикация крови и органов желудочно-кишечного тракта, способная поражать легкие, гепатобилиарную систему, легкие. Заболевание является опасным для жизни.
- Сепсис или общее заражение крови. Посредством циркуляции крови, инфекция разносится по всему организму. Различают несколько разновидностей болезни:
- мгновенный, развивается в форсированном режиме, уже через несколько часов возможен летальный исход;
- острый, со скоростью развития в 1,5 месяца;
- подострый, продолжительностью до 3-х месяцев;
- волнообразный или рецидивирующий, характеризуется периодами ремиссии и обострения;
- хронический или хрониосепсис, может продолжаться несколько лет на фоне систематической соответствующей терапии.
Последние два варианта являются редкой разновидностью сепсиса. В большинстве случаев отмечается высокая смертность пациентов.
Профилактика
Не допустить инфицирования поможет:
- соблюдение санитарно-эпидемиологических норм и правил личной гигиены;
- внимательное отношение к своему здоровью и медицинским учреждениям, выбираемым для лечения;
- тщательное отслеживание сроков годности и качества продуктов питания;
- своевременное лечение порезов, ссадин и других открытых травм кожи;
- лечение хронических патологий;
- поддержание иммунитета на высоком уровне.
Людям со склонностью к хроническим или острым кожным патологиям, целесообразно предупредить заражение посредством вакцинации от стафилококка.
https://youtube.com/watch?v=2Z_TIGYfJi0